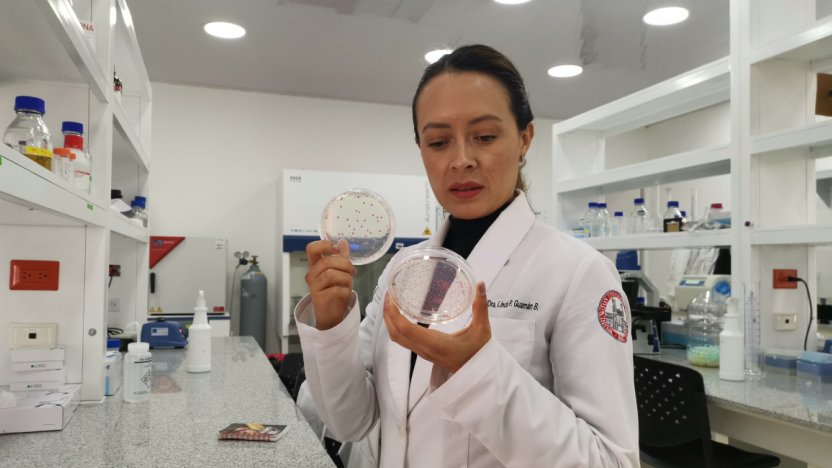

Linda Guamán, científica ecuatoriana, destaca en evento internacional del MIT
La científica ecuatoriana Linda Guamán ha logrado un reconocimiento internacional por su destacada trayectoria en el campo de la ciencia y la tecnología. Su participación y premiación en un evento organizado por el Massachusetts Institute of Technology (MIT) representa un significativo avance para la comunidad científica del Ecuador y pone de manifiesto el talento nacional a nivel global.
Guamán, cuya formación y experiencia se han enfocado en la investigación científica, se posiciona como una figura clave entre las mujeres líderes en disciplinas científicas y tecnológicas, áreas tradicionalmente dominadas por hombres. Su logro no solo destaca su excelencia profesional, sino que también inspira a nuevas generaciones de mujeres ecuatorianas a incursionar en campos STEM (ciencia, tecnología, ingeniería y matemáticas).
Un reconocimiento que trasciende fronteras
El reconocimiento otorgado a Linda Guamán se dio en el marco de un evento organizado por el MIT, una de las instituciones educativas más prestigiosas del mundo. El galardón se otorga a profesionales que demuestran alto impacto en sus campos de estudio, innovación y compromiso con el desarrollo científico.
La notable participación de Guamán reafirma el papel de los investigadores ecuatorianos en escenarios internacionales de alto nivel. Su trabajo fue valorado no solo por su calidad técnica, sino también por la relevancia social que representa para el avance de la ciencia en contextos como el latinoamericano.
Trayectoria y compromiso con la ciencia
Desde sus primeros años en la academia, Linda Guamán se destacó por su dedicación y enfoque en investigaciones que aportan a la comprensión de fenómenos complejos en su área de especialización. A lo largo de su carrera, ha participado en múltiples proyectos, publicaciones y colaboraciones que la han consolidado como una autoridad en su campo.
Su reconocimiento en un evento de la magnitud del MIT es también un reflejo de la importancia de seguir impulsando políticas y espacios que promuevan la participación de mujeres en la ciencia y la tecnología, áreas fundamentales en el mundo actual para el desarrollo sostenible, la innovación y la solución de problemáticas globales.
Inspiración para las nuevas generaciones
El logro de Linda Guamán representa una inspiración para estudiantes, investigadoras e investigadores, especialmente para aquellas mujeres que buscan abrirse camino en disciplinas científicas. Su ejemplo no solo demuestra que es posible alcanzar altos niveles de reconocimiento internacional, sino que también impulsa la esperanza de que nuevos talentos ecuatorianos puedan seguir sus pasos.
El reconocimiento también destaca la necesidad de crear entornos educativos y profesionales que favorezcan la igualdad de oportunidades, la excelencia académica y el desarrollo de investigación de impacto social.

Atributos sostenibles impulsan decisiones de compra en Ecuador: más del 50% muestra apertura a prácticas más sostenibles

Chequeos auditivos gratuitos en 13 ciudades del país

El desarrollo integral y la inclusión ganan visibilidad en el Día Mundial del Síndrome de Down



